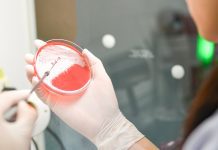
Scientists pioneer new antimicrobial drugs from food by-products antibiotic drugs

Mikael Hoier, CEO of cold storage manufacturer Lowenco, speaks with HE about innovation in low-temperature vaccine storage.
Danish manufacturer Lowenco is an international leader in the development and production of sustainable cold storage facilities – a significant current priority as vaccine rollouts across the world continue apace. CEO Mikael Hoier speaks with HE about the role of ultra-low temperature storage in preserving the integrity of the cold chain for medical products.
What is the significance of the cold chain in maintaining the integrity and efficacy of vaccines? How can Lowenco’s products contribute to this?
Storing vaccines in cold conditions is essential to prevent them from losing their effectiveness or even becoming dangerous to patients; for this reason, high-quality refrigerators and freezers are an essential part of the supply chain. One key aspect of having cold storage in place for vaccines is that it can be adapted to meet long-term storage needs: once the COVID-19 pandemic comes to an end, manufacturers which have been developing and producing vaccines will be able to place any excess products into long-term cold storage. This means that they are ready to be distributed if the need arises again, rather than needing to establish new lines of production any time there is a new pandemic or epidemic of an existing disease. A similar protocol has been in place for the Ebola vaccine.
Naturally, COVID-19 is the most pressing priority at the moment; everyone wants to receive the vaccine as soon as possible. Meanwhile, epidemiologists are investigating the different strains of the virus – there is the Brazilian strain, the British strain and doubtless more will emerge in the future – and their implications for the vaccine. It may become necessary to vaccinate or re-vaccinate people once or even twice a year in the future; and by implementing ultra-low temperature freezer storage, manufacturers will be able to keep on producing at the pace that works for them for one or two or three years, build up sizeable reserves of the vaccine, and then switch production lines back to whatever products they were working on before the pandemic.
This is the beauty of having ultra-low temperature storage on a large scale, which is where we specialise: large-scale ultra-low temperature freezers can hold substantially more products, meaning that manufacturers are able to build up a healthy base of stock and then return to their normal operations, while still retaining the ability to meet new or ongoing demand for vaccines.
Can you tell me a bit about the range of products Lowenco offers?
We offer a large-scale storage solution in the form of the Lowenco Large-Scale Storage Unit (LSSU). The smallest individual unit available is our three-door unit, which has the capacity to store up to 2,400kg of fluid products in bottles, vials or bags at temperatures ranging from 10°C to -80°C. The typical solution we deliver to our customers’ freezer parks is our scalable modular concept with four-door unit, which offers capacity up to 3,200kg inside each freezer. That modular concept means that we can deliver sets of two, four, six or even hundreds of units, with the full flexibility and ability to expand further year after year just by adding more units to the existing installation.
What sets Lowenco’s refrigeration units apart from similar products on the market?
The name Lowenco stands for ‘low-energy cooling’: while the LSSU is a large-scale unit, it has a very low rate of power consumption in comparison to other low-temperature storage options: you would need 40 standard upright freezers to get similar storage capacity to one Lowenco freezer unit, but one of our LSSU large-scale freezer units has a power consumption equal to only six standard upright freezers. One of our primary goals as a company, in everything we do, is to minimise the impact we have on the Earth; this is increasingly a priority for companies within the pharmaceutical space, a growing number of which are striving to establish a greener profile – this is particularly the case in Europe, and US companies will hopefully soon follow suit.
We are very conscious of the high value of the products which are stored inside our freezers by the pharmaceutical companies we serve – of course these companies will want to ensure that their products are fully secure at all times, and that they are handled correctly and appropriately. Our products offer an unparalleled degree of security: each individual freezer unit includes completely redundant systems, meaning that all the mechanical and electrical parts are duplicated and each of the duplicate systems has the necessary cooling capacity to run the whole system unaided. This means that if a component or system breaks or develops a fault, the second system will automatically take over without any running issues or drop in capacity.
This is another significant difference between our products and the standard upright freezers available elsewhere on the market; upright freezers from other manufacturers do not always offer any redundancy at all. Without that redundancy guarantee in place, in the event of a mechanical failure, the user will need to rush to the freezer, empty it completely and store their product in standby freezers. If they do not do this immediately they will have to dispose of the product entirely, as it is no longer safe to use; which would constitute a loss to the user of the full value of any product. Even in the case of large onsite cold rooms, while these rooms are more likely to have some form of redundancy in place, it is often not enough to keep the entire system running at full capacity if something goes wrong. In contrast, every single one of the freezers we supply will have full redundancy in place, simply to secure the product.
Another important aspect to consider is that of human risk. In facilities where walk-in freezers are installed, anyone who needs to access a product or place a product in storage must walk into the freezer, potentially at temperatures of -80°C. At those temperatures, anyone entering the freezer will need specialised low-temperature personal protection equipment (PPE) – otherwise they will die. If you enter a room where the temperature is -80°C without the necessary protective gear, as soon as you breathe in, the cold air will freeze you from the inside and kill you. It is a huge risk. Even if people are equipped with the correct PPE, all it takes is for one item of equipment to be damaged or defective somehow and then they are in serious danger.
In the case of our LSSUs, however, the user just needs to open the door from the outside, and only the products themselves need to enter the freezer. The freezer does not have any moving parts, mechanical processes or electrical components inside the chamber itself: everything is handled from the technical area upstairs from the freezer. From that technical space, users are able to perform full automatic maintenance: everything that needs to be done can be done remotely, so no-one needs to actually enter the freezer itself. Users are safe from risk; and because the freezer doors remain closed and the ambient temperature stays consistent, the products inside the freezer are safe from contamination and temperature fluctuations. I often say to my clients: I do not sell products. I sell safety, both for your product and for your employees.
The process of building onsite cold rooms takes a lot of time, and during the build phase the space cannot be used. In Lowenco’s case, we assemble our cold storage units on our own site, so once they reach the client’s facility they only need to be installed. That limited time we need to spend at the client’s site means there is very little disruption to their workflow; and particularly during the COVID-19 pandemic, we are able to observe social distancing guidelines and avoid long periods of contact with the client’s site and staff.
If a company needs to scale up its production line, it will commonly need to expand its core facility or even construct new buildings, which can take up to six months. If that company reaches out to us at the beginning of its build phase, we can begin work on a new freezer unit before that construction is finished and have it ready once the customer’s new space is open. All the building processes in the Lowenco workshop are modular and scalable, so all we have to do is ascertain how many freezer units the customer needs and adapt accordingly – then, if a customer wants to expand their cold storage capacity later on, we can just add in extra units wherever they are needed. This can be done while the existing units are running; the installation process does not disrupt or obstruct the units which are already in place.
What sustainability measures does the company have in place?
Lowenco supports the United Nations’ (UN) Sustainable Development Goals and is committed to driving affordable, environmentally safe refrigeration. We are focused particularly on eliminating the use of the refrigerant R-23, which has a very high Global Warming Potential (GWP). Its use is already capped within the EU; and our research and development team is working on finding new ways to phase out its use – we would really like to get rid of it altogether.
How do you see Lowenco progressing in the future? Do you plan to expand your range of products?
We are in the process of expanding further into the international market: from our base in in Europe, we have already completed two installations in the US and one large installation is ongoing in India. Lowenco is well on the way to becoming a global supplier for our growing base of clients.
This article is from issue 17 of Health Europa. Click here to get your free subscription today.